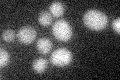
YBR104W
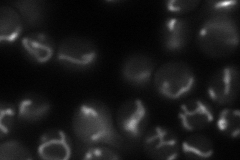
YBR104W
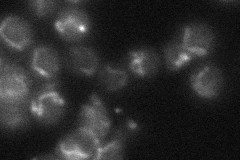
YBR104W

View description
Mitochondrial protein, putative inner membrane transporter with a role in oleate metabolism and glutamate biosynthesis; member of the mitochondrial carrier (MCF) family; has similarity with Ymc1p
Localization:
Intensity:
Fold change:
Significance:
-
C’ GFP library in SD
below threshold14.7 -
N' NOP1pr-GFP in SD
mitochondria84.4372 -
N' TEF2pr-mCherry in SD

mitochondria59.6283 -
N' NATIVEpr-GFP in SD
mitochondria25.1594 -
N' TEF2pr-VC and Cyto-VN in SD

mitochondria28.3156 -
C’ GFP library in SD+DTT

cytosol13.470.91No -
C’ GFP library in SD+H2O2

cytosol15.251.03No -
C’ GFP library in Starvation Media

cytosol14.821No -
C’ GFP library on the background of Pup2-DaMP

below threshold -
C’ GFP library on the background of CCT mutant

below threshold15.75491.07101No
